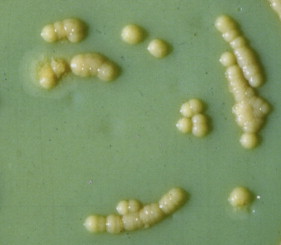
Mycobacterium chelonae - an overview | ScienceDirect Topics

Mycobacterium chelonae subsp. abscessus NTCC®93326龟分枝杆菌脓肿亚种 BioVector NTCC质粒载体菌株细胞蛋白抗体基因保藏中心
- 价 格:¥99850
- 货 号:NTCC®93326
- 产 地:北京
- BioVector NTCC典型培养物保藏中心
- 联系人:Dr.Xu, Biovector NTCC Inc.
电话:400-800-2947 工作微信:1843439339 (QQ同号)
邮件:Biovector@163.com
手机:18901268599
地址:北京
- 已注册
Mycobacterium chelonae subsp. abscessus NTCC®93326龟分枝杆菌脓肿亚种
BioVector NTCC质粒载体菌株细胞蛋白抗体基因保藏中心
Mycobacterium chelonae subsp. abscessus NTCC® 93326 is a specific strain of this rapidly growing mycobacterium.
Key Points:.
Mycobacterium chelonae subsp. abscessus: This is a rapidly growing mycobacterium, a type of bacteria that can cause various infections in humans, including skin infections, lung infections, and disseminated disease.
Rapidly Growing Mycobacteria (RGM): These mycobacteria grow much faster than the more familiar Mycobacterium tuberculosis and other slow-growing mycobacteria.
Significance of ATCC 93326:
Research Strain: This strain likely serves as a valuable resource for research purposes, such as:
Studying the pathogenesis of M. chelonae subsp. abscessus infections.
Developing new diagnostic tests and treatments.
Investigating the mechanisms of antibiotic resistance.
Vaccine development.
Quality Control: It might be used as a reference strain for:
Quality control in diagnostic laboratories.
Evaluating the efficacy of disinfectants.
Important Considerations:
Safety:M. chelonae subsp. abscessus can cause infections in humans. It's crucial to handle this strain with appropriate safety precautions in a biosafety laboratory.
Antibiotic Resistance: These bacteria are often resistant to multiple antibiotics, making treatment challenging.
Image

生产厂家Supplier:
BioVector NTCC质粒载体菌株细胞蛋白抗体基因保藏中心
E-mail:BioVector@163.com
- 公告/新闻




